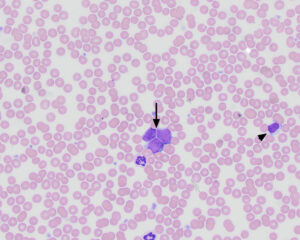

There are three intermediate to large cells (“other WBC”) with small amounts of light to medium blue cytoplasm, fine nuclear chromatin and 1-2 indistinct nucleoli (arrow). Compare the size and nuclear chromatin of these three cells with the small lymphocyte (arrowhead), which has slightly more clumped chromatin and no nucleoli. Given that the cells were identified in the first hemogram from the dog three months prior and there was a lack of cytopenias, the cells were interpreted as being neoplastic lymphocytes (Modified Wright stain, 50x objective)